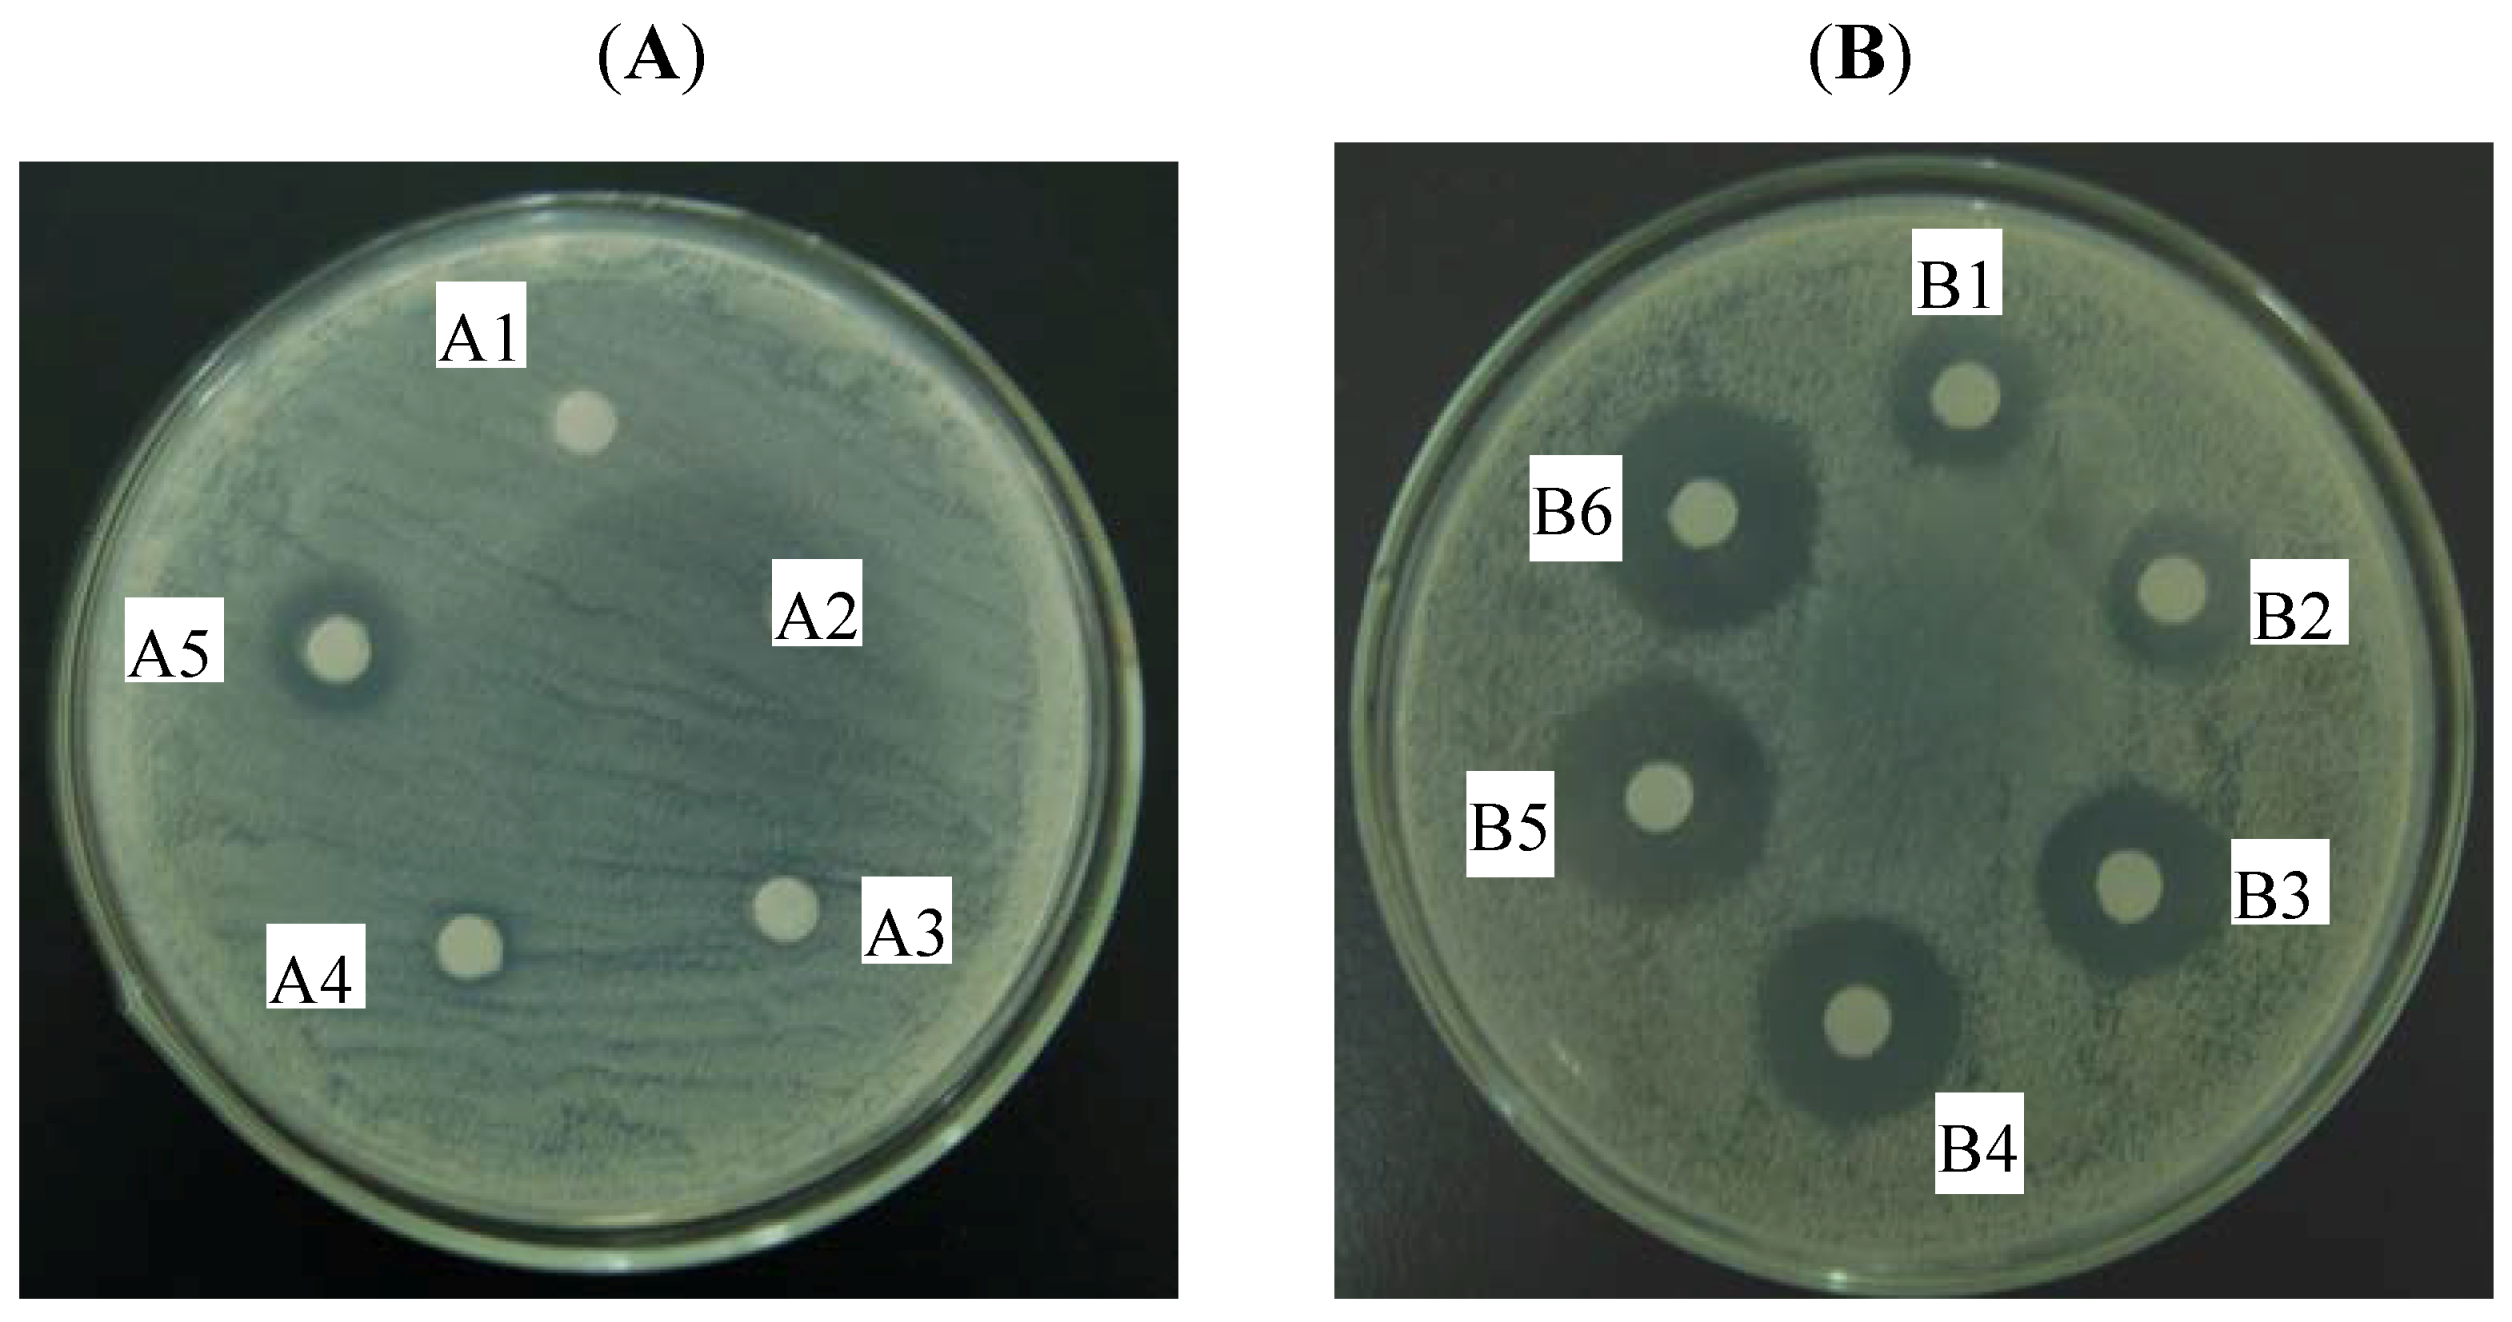

In Vitro Synergy of Biochanin A and Ciprofloxacin against Clinical Isolates of Staphylococcus aureus
Abstract
:1. Introduction
2. Results
2.1. Drug Effect Alone and in Combination
2.2. Time-Kill Curves
2.3. Agar Diffusion Test
3. Discussion
4. Experimental
4.1. Bacterial Strains and Reagents
4.2. Medium
4.3. Drug Susceptibility Testing
4.4. Checkerboard Assay
4.5. Drug Interaction Interpretation
4.6. Time-Kill Curves
4.7. Agar Diffusion Test
5. Conclusions
Acknowledgements
Conflict of interest
Reference and Notes
- Li, D.; Cheung, A. Repression of hla by rot is dependent on sae in Staphylococcus aureus. Infect. Immun. 2008, 76, 1068–1075. [Google Scholar] [CrossRef] [PubMed]
- Klevens, R.M.; Gorwitz, R.J.; Collins, A.S. Methicillin-resistant Staphylococcus aureus: A primer for dentists. J. Am. Dent. Assoc. 2008, 139, 1328–1337. [Google Scholar] [CrossRef] [PubMed]
- Ayliffe, G.A. The progressive intercontinental spread of methicillin-resistant Staphylococcus aureus. Clin. Infect. Dis. 1997, 24 (Suppl. 1), S74–S79. [Google Scholar] [CrossRef]
- Paulsen, I.T.; Firth, M.; Skurray, R.A. Resistance to antimicrobial agents other than b-lactams. In The Staphylococci in Human Disease; Crossley, K.B., Archer, G.L., Eds.; Churchill Livingstone: New York, NY, USA, 1997; pp. 175–212. [Google Scholar]
- Kuroda, H.; Kuroda, M.; Cui, L.; Hiramatsu, K. Subinhibitory concentrations of beta-lactam induce haemolytic activity in Staphylococcus aureus through the SaeRS two-component system. FEMS Microbiol. Lett. 2007, 268, 98–105. [Google Scholar] [CrossRef] [PubMed]
- Rios, J.L.; Recio, M.C. Medicinal plants and antimicrobial activity. J. Ethnopharmacol. 2005, 100, 80–84. [Google Scholar] [CrossRef] [PubMed]
- Li, L.; Li, Z.; Guo, N.; Jin, J.; Du, R.; Liang, J.; Wu, X.; Wang, X.; Liu, M.; Jin, Q.; Yu, L. Synergistic activity of 1-(1-naphthylmethyl)-piperazine with ciprofloxacin against clinically resistant Staphylococcus aureus, as determined by different methods. Lett. Appl. Microbiol. 2011, 52, 372–378. [Google Scholar] [CrossRef] [PubMed]
- Cushnie, T.P.T.; Lamb, A.J. Antimicrobial activity of flavonoids. Int. J. Antimicrob. Agents 2005, 26, 343–356. [Google Scholar] [CrossRef] [PubMed]
- Lechner, D.; Gibbons, S.; Bucar, F. Plant phenolic compounds as ethidium bromide efflux inhibitors in Mycobacterium smegmatis. J. Antimicrob. Chemother. 2008, 62, 345–348. [Google Scholar] [CrossRef] [PubMed]
- Dastidar, S.G.; Manna, A.; Kumar, K.A.; Mazumdar, K.; Dutta, N.K.; Chakrabarty, A.N.; Motohashi, N.; Shirataki, Y. Studies on the antibacterial potentiality of isoflavones. Int. J. Antimicrob. Agents 2004, 23, 99–102. [Google Scholar] [CrossRef] [PubMed]
- Flythe, M.; Kagan, I. Antimicrobial effect of red clover (Trifolium pratense) phenolic extract on the ruminal hyper ammonia-producing bacterium, Clostridium sticklandii. Curr. Microbiol. 2010, 61, 125–131. [Google Scholar] [CrossRef] [PubMed]
- Sklenickova, O.; Flesar, J.; Kokoska, L.; Vlkova, E.; Halamova, K.; Malik, J. Selective growth inhibitory effect of biochanin A against intestinal tract colonizing bacteria. Molecules 2010, 15, 1270–1279. [Google Scholar] [CrossRef] [PubMed]
- Medjakovic, S.; Jungbauer, A. Red clover isoflavones biochanin A and formononetin are potent ligands of the human aryl hydrocarbon receptor. J. Steroid. Biochem. Mol. Biol. 2008, 108, 171–177. [Google Scholar] [CrossRef] [PubMed]
- Shen, P.; Liu, M.H.; Ng, T.Y.; Chan, Y.H.; Yong, E.L. Differential effects of isoflavones, from Astragalus membranaceus and Pueraria thomsonii, on the activation of PPARa, PPARg, and adipocyte differentiation in vitro. J. Nutr. 2006, 136, 899–905. [Google Scholar] [CrossRef] [PubMed]
- Lee, Y.S.; Seo, J.S.; Chung, H.T.; Jang, J.J. Inhibitory effects of biochanin A on mouse lung tumor induced by benzo(a)pyrene. J. Kor. Med. Sci. 1991, 6, 325–328. [Google Scholar] [CrossRef] [PubMed]
- Cassady, J.M.; Zennie, T.M.; Chae, Y.H.; Ferin, M.A.; Portuondo, N.E.; Baird, W.M. Use of a mammalian cell culture benzo(a)pyrene metabolism assay for the detection of potential anticarcinogens from natural products: Inhibition of metabolism by biochanin A, an isoflavone from Trifolium pratense L. Cancer Res. 1988, 48, 6257–6261. [Google Scholar] [PubMed]
- Oo, T.Z.; Cole, N.; Garthwaite, L.; Willcox, M.D.; Zhu, H. Evaluation of synergistic activity of bovine lactoferricin with antibiotics in corneal infection. J. Antimicrob. Chemother. 2010, 65, 1243–1251. [Google Scholar] [CrossRef] [PubMed]
- Li, Y.; Sun, S.; Guo, Q.; Ma, L.; Shi, C.; Su, L.; Li, H. In vitro interaction between azoles and cyclosporin a against clinical isolates of Candida albicans determined by the chequerboard method and time-kill curves. J. Antimicrob. Chemother. 2008, 61, 577–585. [Google Scholar] [CrossRef] [PubMed]
- Weidenborner, M.; Hindorf, H.; Jha, H.C.; Tsotsonos, P.; Egge, H. Antifungal activity of isoflavonoids in different reduced stages on Rhizoctonia solani and Sclerotium rolfsii. Phytochemistry 1990, 29, 801–803. [Google Scholar] [CrossRef]
- Kramer, R.P.; Hindorf, H.; Jha, H.C.; Kallage, J.; Zilliken, F. Antifungal activity of soybean and chickpea isoflavonec and their reduced derivatives. Phytochemistry 1984, 23, 2203–2205. [Google Scholar] [CrossRef]
- Rojas, R.; Bustamante, B.; Ventosilla, P.; Fernadez, I.; Caviedes, L.; Gilman, R.H.; Lock, O.; Hammond, G.B. Larvicidal, antimycobacterial and antifungal compounds from the bark of the Peruvian plant Swartzia polyphylla DC. Chem. Pharm. Bull. 2006, 54, 278–279. [Google Scholar] [CrossRef] [PubMed]
- Sklenickova, O.; Flesar, J.; Kokoska, L. Selective antimicrobial activity of isoflavonoids. Ann. Nutr. Metab. 2009, 55, 391. [Google Scholar]
- Tsuchiya, H.; Sato, M.; Miyazaki, T.; Fujiwara, S.; Tanigaki, S.; Ohyama, M.; Tanaka, T.; Iinuma, M. Comparative study on the antibacterial activity of phytochemical flavanones against methicillin-resistant Staphylococcus aureus. J. Ethnopharmacol. 1996, 50, 27–34. [Google Scholar] [CrossRef]
- Drlica, K.; Zhao, X. DNA gyrase, topoisomerase IV, and the 4-quinolones. Microbiol. Mol. Biol. Rev. 1997, 61, 377–392. [Google Scholar] [PubMed]
- Hooper, D.C. Mechanisms of fluoroquinolone resistance. Drug Resist. Updat. 1999, 2, 38–55. [Google Scholar] [CrossRef] [PubMed]
- Becnel Boyd, L.; Maynard, M.J.; Morgan-Linnell, S.K.; Horton, L.B.; Sucgang, R.; Hamil, R.J.; Jimenez, J.R.; Versalovic, J.; Steffen, D.; Zechiedrich, L. Relationships among ciprofloxacin, gatifloxacin, levofloxacin, and norfloxacin MICs for fluoroquinolone-resistant Escherichia coli Clinical Isolates. Antimicrob. Agents Chemother. 2009, 53, 229–234. [Google Scholar] [CrossRef] [PubMed]
- Cirz, R.T.; Jones, M.B.; Gingles, N.A.; Minogue, T.D.; Jarrahi, B.; Peterson, S.N.; Romesberg, F.E. Complete and SOS-mediated response of Staphylococcus aureus to the antibiotic ciprofloxacin. J. Bacteriol. 2007, 189, 531–539. [Google Scholar] [CrossRef] [PubMed]
- Froelich-Ammon, S.J.; Osheroff, N. Topoisomerase poisons: Harnessing the dark side of enzyme mechanism. J. Biol. Chem. 1995, 270, 21429–21432. [Google Scholar] [CrossRef] [PubMed]
- Drlica, K.; Malik, M.; Kerns, R.J.; Zhao, X. Quinolone-mediated bacterial death. Antimicrob. Agents Chemother. 2008, 52, 385–392. [Google Scholar] [CrossRef] [PubMed]
- Clinical and Laboratory Standards Institute. Methods for Dilution Antimicrobial Susceptibility Tests for Bacteria That Grow Aerobically, 8th ed.; CLSI: Wayne, PA, USA, 2009. [Google Scholar]
- Jacqueline, C.; Navas, D.; Batard, E.; Miegeville, A.F.; Le Mabecque, V.; Kergueris, M.F.; Bugnon, D.; Potel, G.; Caillon, J. In vitro and in vivo synergistic activities of linezolid combined with subinhibitory concentrations of imipenem against methicillin-resistant Staphylococcus aureus. Antimicrob. Agents Chemother. 2005, 49, 45–51. [Google Scholar] [CrossRef] [PubMed]
- Santos, A.O.; Ueda-Nakamura, T.; Dias Filho, B.P.; Veiga Junior, V.F.; Pinto, A.C.; Nakamura, C.V. Antimicrobial activity of Brazilian copaiba oils obtained from different species of the Copaifera genus. Mem. Inst. Oswaldo Cruz 2008, 103, 277–281. [Google Scholar] [CrossRef] [PubMed]
- Périchon, B.; Courvalin, P. Synergism between β-lactams and glycopeptides against VanA-type methicillin-resistant Staphylococcus aureus and heterologous expression of the vanA operon. Antimicrob. Agents Chemother. 2006, 50, 3622–3630. [Google Scholar] [CrossRef] [PubMed]
Sample Availability: Samples of the compounds biochanin A is available from the authors. |

, no drug control; □, CPFX; ▲, BCA; *, CPFX plus BCA.
, no drug control; □, CPFX; ▲, BCA; *, CPFX plus BCA.
| Strains | Median MIC (range) of drug (µg/mL) | |||
|---|---|---|---|---|
| Alone | In combination | |||
| BCA | CPFX | BCA | CPFX | |
| S. aureus 1662 | 256 (128–256) | 256 (256) | 32 (32–64) | 32 (32–64) |
| S. aureus 3633 | 128 (128–256) | 256 (256) | 16 (8–16) | 8 (8) |
| S. aureus 3814 | 128 (128) | 256 (128–256) | 32 (16–32) | 64 (32–64) |
| S. aureus 3725 | 256 (256–512) | 256 (256) | 32 (32–64) | 16 (16–32) |
| S. aureus 2855 | 128 (128–256) | 256 (128–256) | 8 (8–16) | 16 (8–16) |
| S. aureus 1881 | 128 (128–256) | 256 (256) | 32 (32–64) | 32 (32–64) |
| S. aureus 3014 | 256 (256) | 256 (128–256) | 32 (32–64) | 32 (32–64) |
| S. aureus 3115 | 256 (128–256) | 128 (128–256) | 64 (32–64) | 32 (32–64) |
| S. aureus 3451 | 256 (256–512) | 256 (256–512) | 32 (32–64) | 8 (8–16) |
| S. aureus 3182 | 256 (256–512) | 256 (256) | 64 (64–128) | 32 (32) |
| S. aureus 1787 | 512 (256–512) | 256 (128–256) | 64 (32–64) | 32 (32–64) |
| S.aureus ATCC 25923 | 64 (64) | 1 (1) | 16 (4–16) | 0.25 (0.25) |
| Strains | Nonparametric method * | |
|---|---|---|
| Fractional Inhibitory Concentration Index (FICI) | ||
| Mean(range) | Interpretation | |
| S. aureus 1662 | 0.25 (0.25) | SYN |
| S. aureus 3633 | 0.16 (0.06–0.16) | SYN |
| S. aureus 3814 | 0.38 (0.25–0.50) | SYN |
| S. aureus 3725 | 0.19 (0.09–0.31) | SYN |
| S. aureus 2855 | 0.13 (0.06–0.25) | SYN |
| S. aureus 1881 | 0.38 (0.38–0.50) | SYN |
| S. aureus 3014 | 0.38 (0.25–0.5) | SYN |
| S. aureus 3115 | 0.50 (0.38–0.50) | SYN |
| S. aureus 3451 | 0.16 (0.08–0.31) | SYN |
| S. aureus 3182 | 0.38 (0.38) | SYN |
| S. aureus 1787 | 0.25 (0.25–0.38) | SYN |
| S.aureus ATCC 25923 | 0.50 (0.31–0.50) | SYN |
© 2011 by the authors; licensee MDPI, Basel, Switzerland. This article is an open access article distributed under the terms and conditions of the Creative Commons Attribution license (http://creativecommons.org/licenses/by/3.0/).
Share and Cite
Liu, G.; Liang, J.-C.; Wang, X.-L.; Li, Z.-H.; Wang, W.; Guo, N.; Wu, X.-P.; Shen, F.-G.; Xing, M.-X.; Liu, L.-H.; et al. In Vitro Synergy of Biochanin A and Ciprofloxacin against Clinical Isolates of Staphylococcus aureus. Molecules 2011, 16, 6656-6666. https://doi.org/10.3390/molecules16086656
Liu G, Liang J-C, Wang X-L, Li Z-H, Wang W, Guo N, Wu X-P, Shen F-G, Xing M-X, Liu L-H, et al. In Vitro Synergy of Biochanin A and Ciprofloxacin against Clinical Isolates of Staphylococcus aureus. Molecules. 2011; 16(8):6656-6666. https://doi.org/10.3390/molecules16086656
Chicago/Turabian StyleLiu, Guoxing, Jun-Chao Liang, Xue-Lin Wang, Zhao-Hui Li, Wei Wang, Na Guo, Xiu-Ping Wu, Feng-Ge Shen, Ming-Xun Xing, Li-Hui Liu, and et al. 2011. "In Vitro Synergy of Biochanin A and Ciprofloxacin against Clinical Isolates of Staphylococcus aureus" Molecules 16, no. 8: 6656-6666. https://doi.org/10.3390/molecules16086656
APA StyleLiu, G., Liang, J.-C., Wang, X.-L., Li, Z.-H., Wang, W., Guo, N., Wu, X.-P., Shen, F.-G., Xing, M.-X., Liu, L.-H., Li, L., Liu, M.-Y., & Yu, L. (2011). In Vitro Synergy of Biochanin A and Ciprofloxacin against Clinical Isolates of Staphylococcus aureus. Molecules, 16(8), 6656-6666. https://doi.org/10.3390/molecules16086656
